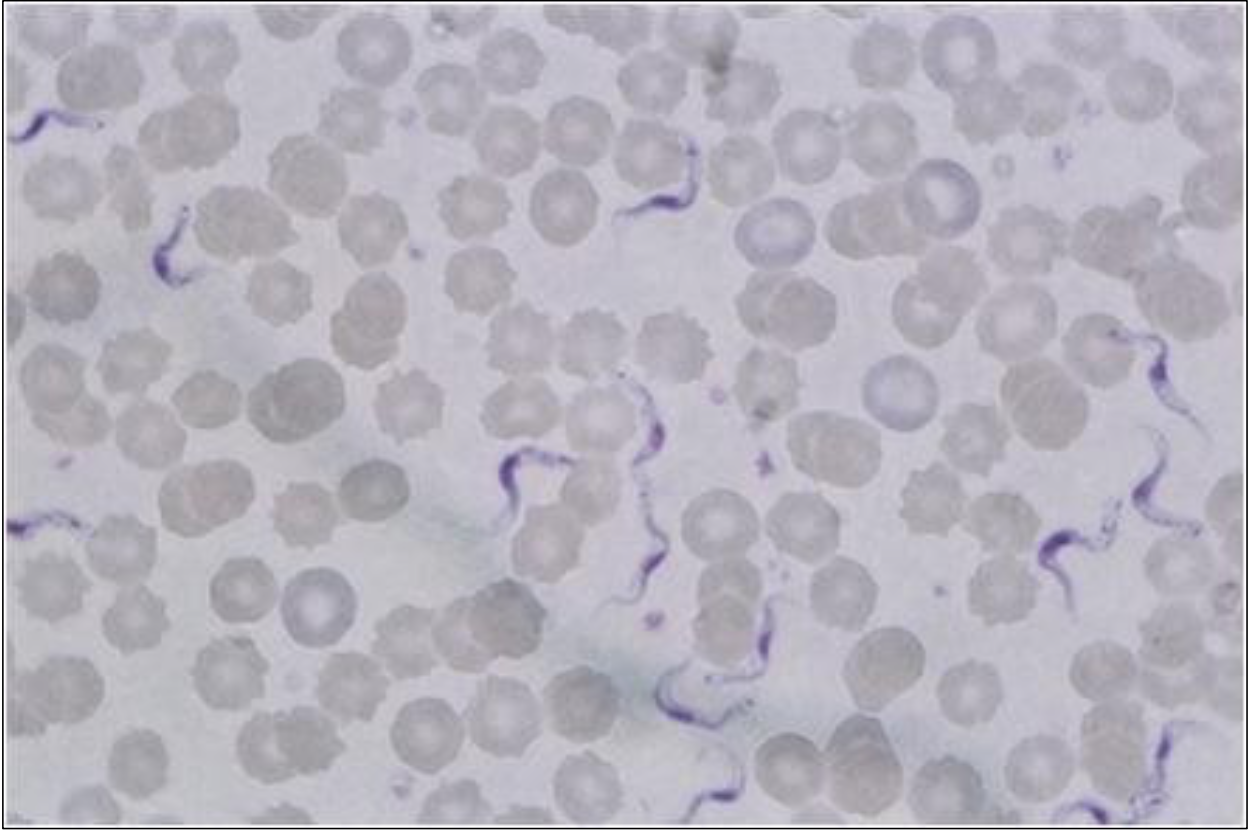
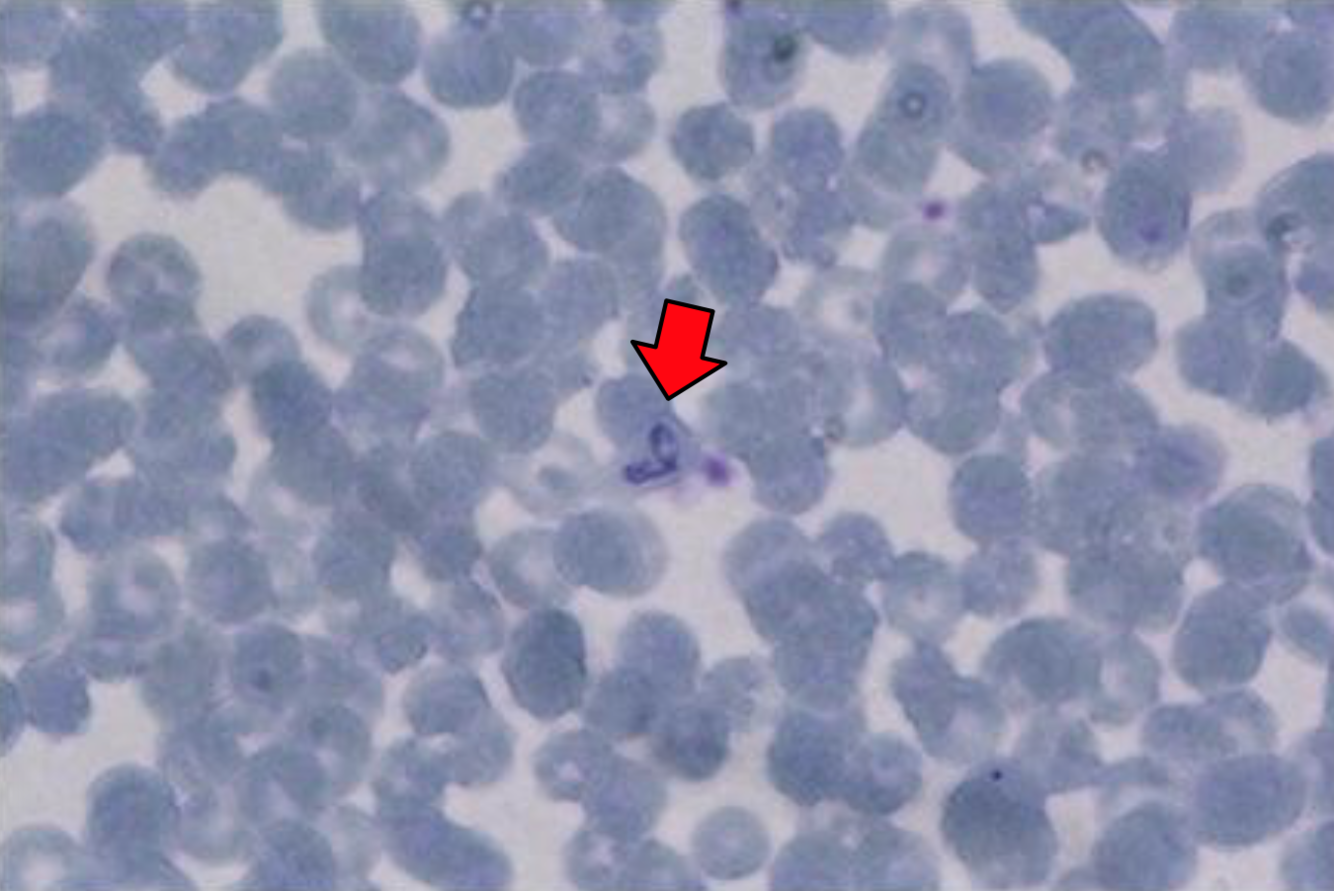
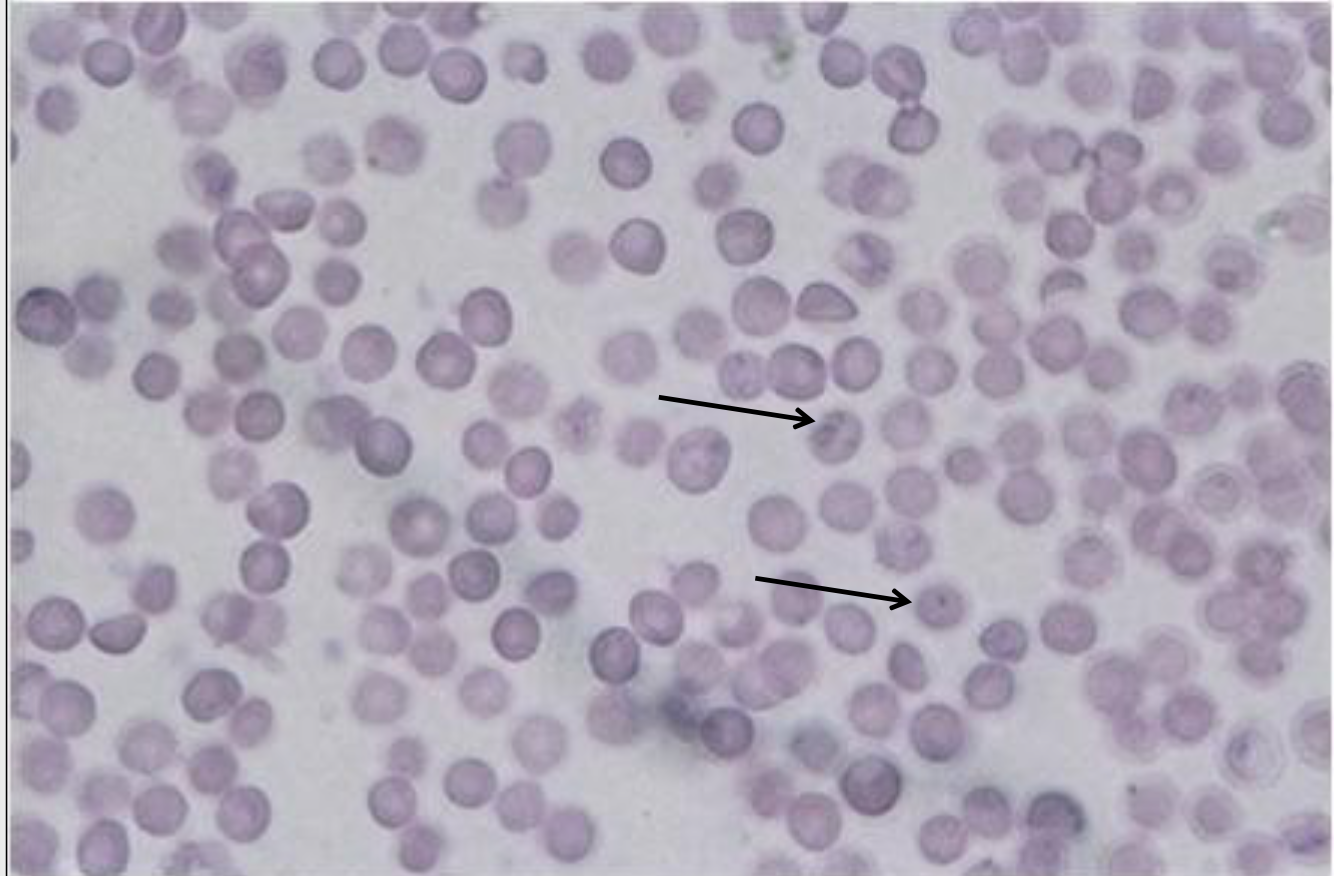
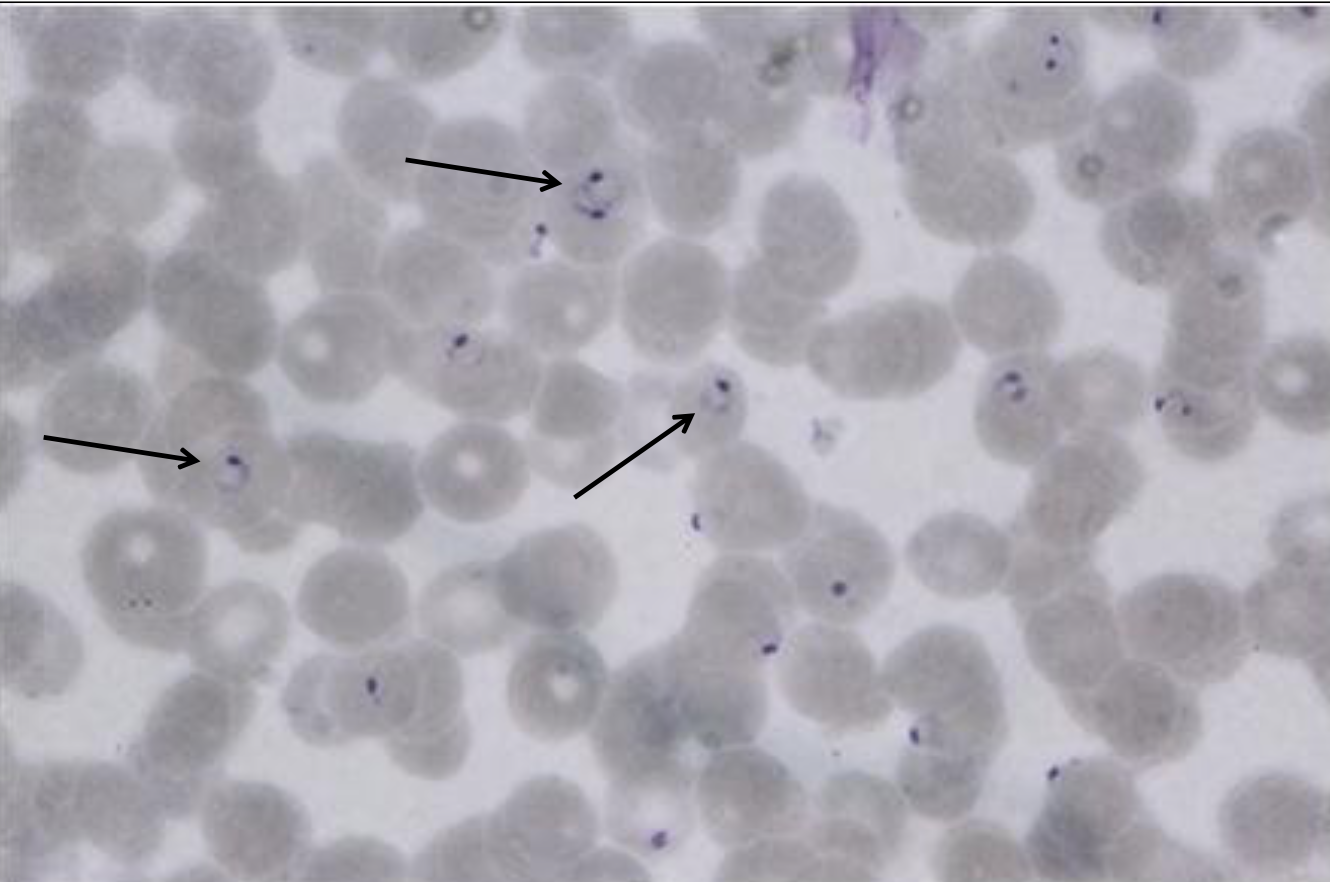
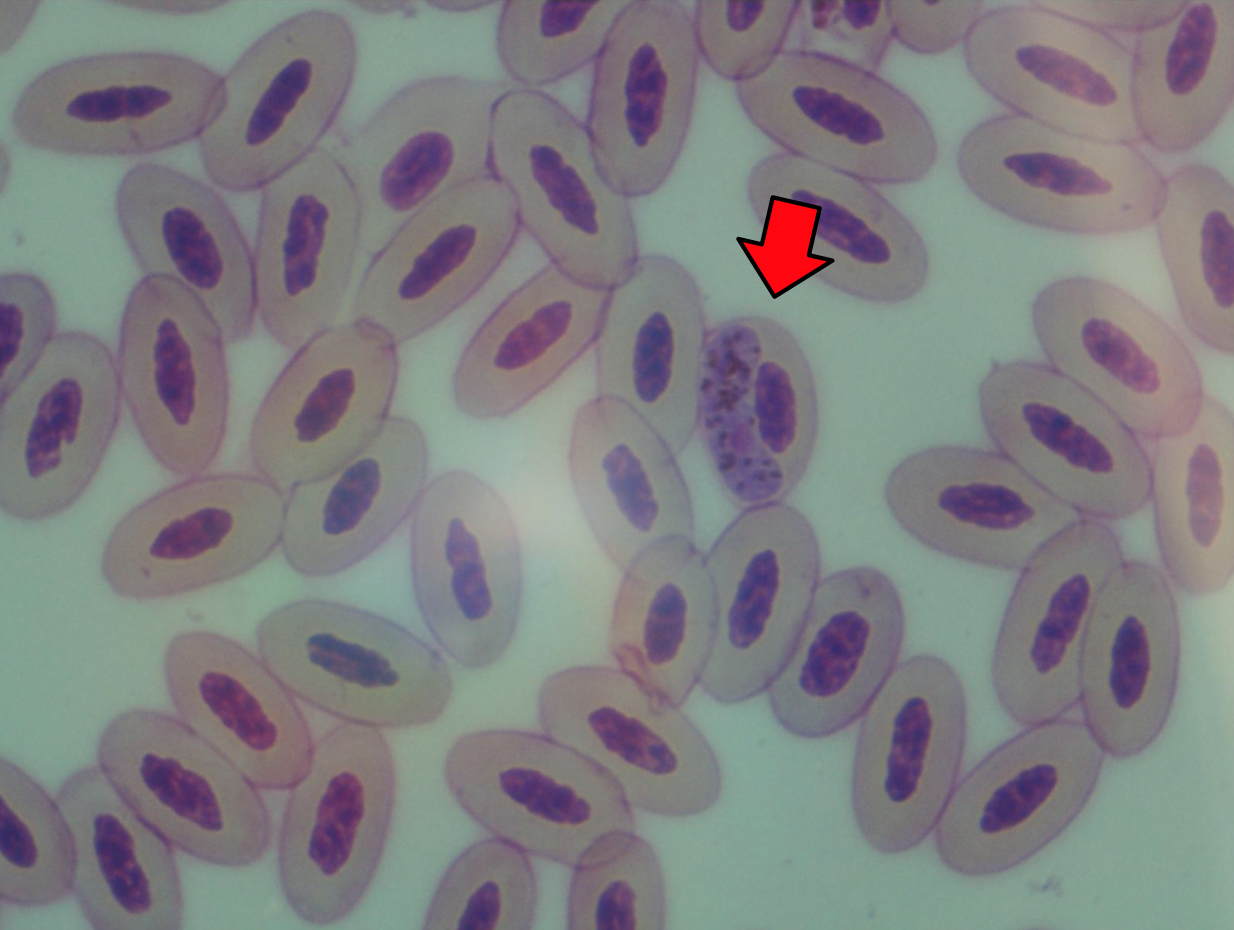

Entamoeba: kyste

Entamoeba: trophozoïte

Balantidium: kyste

Balantidium: trophozoïte

Giardia: kystes

Giardia: trophozoïtes

Giardia: trophozoïte

Trichomonas: trophozoïtes

Trichomonas: trophozoïte
Trypanosoma: tripomastigote sur frotis sanguin

Leishmania: promastigotes (dans vecteur)

Leishmania: amastigotes (dans moelle oseuse)

Eimeria: ookystes sporulés

Cryptosporidium: ookystes sporulés. Coloration Heine

Cryptosporidium: ookystes sporulés.
Coloration de Ziehl-Neelsen

Sarcocystis: kystes musculaires sur coupe hystologique

Toxoplasma: zoïtes
Babesia: mérozoïte sur frotis sanguin

Babesia: mérozoïte sur frotis sanguin
Theileria: mérozoïte sur frotis sanguíneo
Plasmodium: trophozoïte sur frotis sanguin
Haemoproteus: gamonte sur frotis sanguin

Leucocytozoon: gamonte sur frotis sanguin

Kyste macroscopique de Sarcocystis



